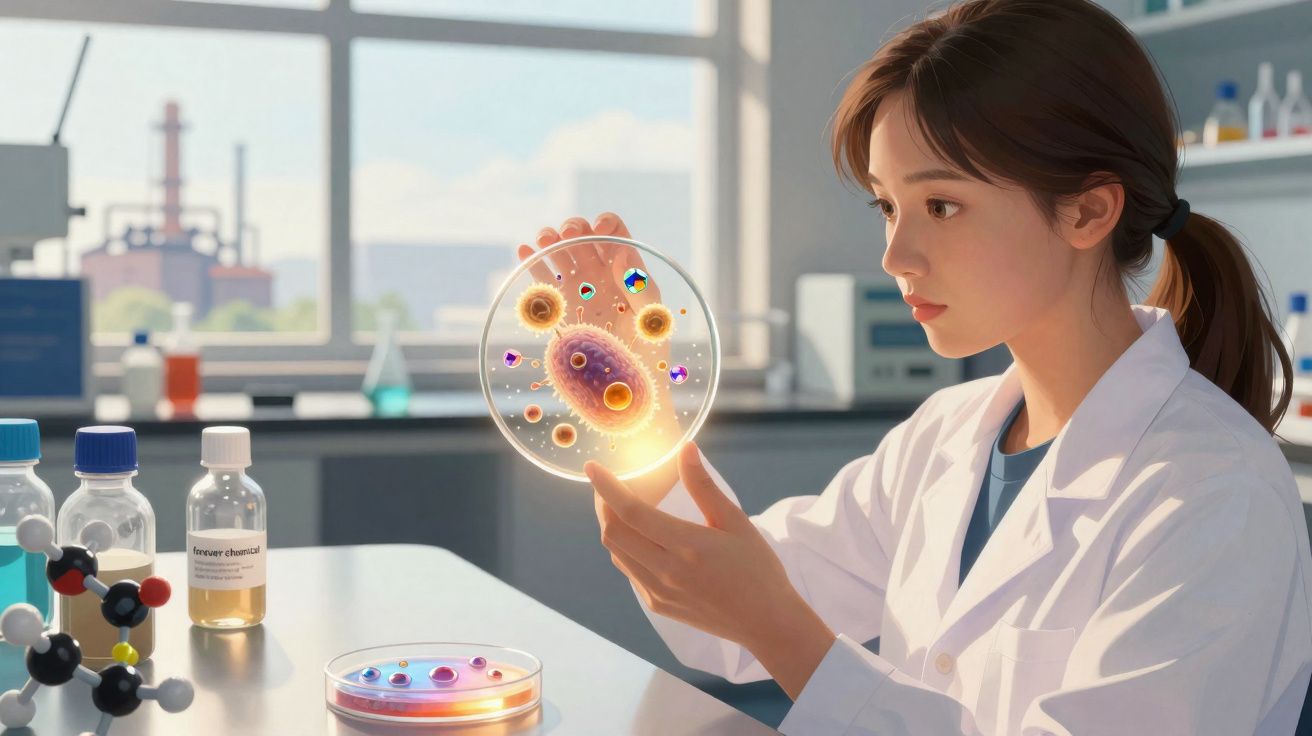
Jovem cientista a observar microorganismos brilhantes numa placa de Petri num laboratório moderno.

Uma decisão errada sobre rega, fertilizante ou controlo de pragas pode custar aos agricultores tempo, dinheiro e colheitas inteiras. Mas um novo estudo sugere que essas decisões poderão em breve ser testadas antes mesmo de chegarem ao terreno.
Os investigadores desenvolveram uma réplica digital de uma exploração que consegue simular condições reais e orientar decisões sobre as culturas com 87.5 por cento de precisão em testes iniciais.
O objetivo é simples: retirar parte do risco da agricultura, transformando a incerteza em algo que os agricultores possam ver e usar antes do momento da decisão.
Construir um gémeo digital agrícola
Num ambiente de exploração simulada, fluxos vindos de drones, sensores no terreno e satélites convergem num único sistema que reproduz as condições reais do campo.
Ao ligar esses sinais em tempo real aos resultados previstos, investigadores da Universidade do Tennessee (UT) mostraram que o sistema consegue associar os pedidos dos agricultores às ações corretas, ao mesmo tempo que filtra escolhas inseguras.
O desempenho manteve-se em cenários de teste variados, onde o sistema aplicou regras adequadas e corrigiu violações antes de qualquer decisão chegar ao campo.
Ainda assim, estes resultados dizem respeito a condições controladas, deixando em aberto de que forma a mesma fiabilidade se manterá quando as explorações reais enfrentarem clima imprevisível, pragas e variação do solo.
O tempo muda tudo
Nos milheirais, a lagarta-do-cartucho, uma praga que se espalha depressa e se alimenta das culturas, já se expandiu para mais de 80 países para lá da sua área de origem.
Entretanto, a agricultura utiliza cerca de 70 por cento das retiradas globais de água doce, o que torna cada erro de rega dispendioso.
O excesso de fertilizante também se perde do solo, porque os microrganismos transformam o azoto excedente em gases ou em escorrência que as culturas nunca aproveitam.
Os alertas precoces valem mais do que médias amplas quando pragas, seca e perdas de nutrientes podem mudar rapidamente.
Problemas na exploração digital
Por cima de um campo, os drones recolhem imagens hiperespectrais - fotografias em várias bandas de luz - que podem revelar stress nas culturas antes de as folhas mudarem visivelmente.
Quando essas varrimentos assinalam zonas problemáticas, as equipas no terreno recolhem amostras para que testes rápidos identifiquem a causa.
Os resultados do ar e do solo entram depois no modelo, onde as condições atuais são comparadas com os cenários mais prováveis a seguir.
Os agricultores precisam dessa cadeia completa, porque uma mancha amarela pode significar coisas muito diferentes - falta de água, falta de nutrientes ou os primeiros sinais de doença.
No gémeo digital do sistema - uma cópia virtual viva da exploração - o programa transforma esses sinais em regras claras e utilizáveis. Em 85 casos de teste, a estrutura associou pedidos em linguagem simples às ações corretas em 87.5 por cento das vezes.
O sistema também acrescenta uma camada de proteção. As verificações digitais fizeram cumprir os limites de segurança em 88 por cento dos casos e corrigiram todas as violações detetadas antes de qualquer coisa chegar ao campo.
Essa filtragem é importante, porque uma má recomendação poderia ultrapassar em silêncio limites de rega, calendários de pulverização ou regras de colheita antes de alguém se aperceber.
Orientação simples para agricultores
A linguagem clara é essencial porque a maioria dos produtores precisa de uma decisão, não de um painel cheio de gráficos e escalas de cores. Os investigadores usam um modelo linguístico de grande dimensão para converter padrões dos sensores em recomendações curtas.
O autor principal do estudo, Charles Cao, é professor associado no Departamento de Engenharia Elétrica e Ciência da Computação da UT.
“Trata-se de pôr ferramentas práticas nas mãos de agricultores em todo o mundo - ferramentas que os ajudem a produzir mais alimentos com menos recursos e menos risco”, afirmou Cao.
Conselhos em linguagem simples podem alargar o acesso, sobretudo às explorações mais pequenas que não conseguem contratar especialistas técnicos ou analistas de dados.
Partilhar sem expor dados
Como o projeto abrange quatro países, a equipa criou aprendizagem federada, treinando modelos partilhados sem mover os dados brutos das explorações.
“A nossa abordagem cria um sistema de IA que fica mais inteligente com a experiência global, sem que qualquer país ou exploração tenha de partilhar os seus dados brutos”, disse Cao.
O treino local é importante porque os registos das explorações podem revelar a gestão da terra, a estratégia comercial e padrões ambientais que os agricultores talvez não queiram expor.
O trabalho em conjunto internacional também se torna mais fácil quando as leis de privacidade, os padrões meteorológicos e as práticas agrícolas diferem de forma tão acentuada.
Agricultura fora da rede
Longe de uma banda larga estável, o grupo está a integrar computação na extremidade diretamente em drones e sensores, para que os dados possam ser processados no próprio dispositivo em vez de dependerem de servidores remotos.
Esse processamento a bordo permite que os aparelhos detetem, em tempo real, stress nas culturas, pragas e condições do solo.
Depois, rádios de baixo consumo enviam pequenos pacotes de dados a grandes distâncias, mantendo os sistemas atualizados mesmo em áreas remotas. Ao reduzir a dependência da internet, a abordagem pode chegar a produtores que muitas vezes ficam de fora de serviços digitais caros.
O projeto está agora a sair da teoria e a entrar no terreno. Os primeiros protótipos de sensores estavam previstos para ser instalados na primavera de 2026, assinalando a passagem dos testes de laboratório para a utilização no mundo real.
No âmbito deste esforço mais vasto, uma equipa de engenharia sediada no Missouri trabalha em conjunto com colaboradores do Japão, da Índia e da Austrália. A Fundação Nacional de Ciência selecionou o projeto em fevereiro de 2026 como uma de seis novas iniciativas.
Os objetivos são ambiciosos: reduzir as perdas de culturas em 20 a 30 por cento, ao mesmo tempo que diminui o uso de água e fertilizante em cerca de 20 por cento.
As explorações reais testam o sistema
Mesmo os números iniciais mais fortes vêm de testes controlados, e não de anos de resultados de colheita em explorações comerciais. As oscilações do clima, as pragas locais, as variedades de culturas e a pressão do mercado ainda podem fazer ruir planos digitais bem montados quando se entra no terreno.
O julgamento humano continua, por isso, no centro, porque um modelo pode hierarquizar opções, mas não pode assumir o risco do fracasso. Os ensaios de campo carregam agora com o peso de provar essa promessa para lá dos casos de teste cuidadosamente desenhados.
Ao mesmo tempo, o projeto de Cao foi concebido para colmatar muitas dessas lacunas do mundo real, juntando aviso antecipado, automatização mais segura, aconselhamento mais claro e dados protegidos num único sistema à escala da exploração.
Se os ensaios de campo confirmarem os resultados iniciais, os agricultores poderão ensaiar decisões antes de as tomar e reduzir as perdas mais cedo.

Comentários
Ainda não há comentários. Seja o primeiro!
Deixar um comentário